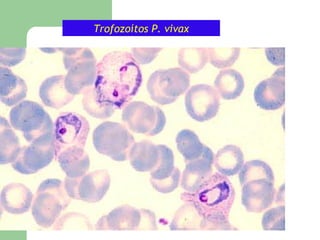
Trofozoítos P. vivax

Este documento describe las diferentes formas y características de los microgametocitos y macrogametocitos de cuatro especies de Plasmodium: P. falciparum, P. ovale, P. malariae y P. vivax. Explica las diferencias en el tamaño, la forma, la localización de la cromatina y el pigmento entre las especies. También presenta fotos de las diferentes etapas del ciclo de vida de Plasmodium en el huésped humano y el mosquito.